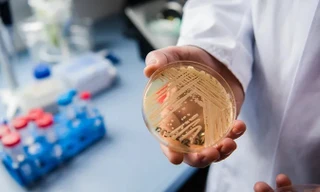
'Siêu vi khuẩn' gây chết người và kháng thuốc đang lan rộng

Những người ủng hộ hydro kỳ vọng trong tương lai, nhiên liệu này có thể được sản xuất và sử dụng trên quy mô lớn trong lĩnh vực giao thông vận tải và các ngành công nghiệp nặng, đóng vai trò là giải pháp thay thế sạch cho nhiên liệu hóa thạch do khi sử dụng chỉ thải ra hơi nước.
Tuy nhiên, nghiên cứu được công bố trên tạp chí Nature cho thấy hydro đã góp phần vào sự gia tăng nhiệt độ toàn cầu bằng cách giúp methane, một loại khí nhà kính mạnh tồn tại lâu hơn trong khí quyển.

Theo nghiên cứu, lượng phát thải hydro đã tăng trong giai đoạn 1990–2020, đóng góp khoảng một phần nhỏ của một độ C tương đương 0,02°C vào mức tăng gần 1,5°C của nhiệt độ trung bình toàn cầu kể từ thời kỳ tiền công nghiệp.
Theo Rob Jackson, nhà khoa học tại Đại học Stanford và là tác giả chính của nghiên cứu: “Chúng ta cần hiểu sâu hơn về chu trình hydro toàn cầu và mối liên hệ của nó với hiện tượng nóng lên toàn cầu để hỗ trợ một nền kinh tế hydro an toàn cho khí hậu và bền vững”.
Nghiên cứu do một nhóm khoa học quốc tế thuộc dự án Global Carbon Project thực hiện cho thấy sự gia tăng phát thải hydro chủ yếu bắt nguồn từ các hoạt động của con người. Theo các nhà nghiên cứu, sự gia tăng này có liên quan chặt chẽ đến lượng methane phát thải ngày càng lớn từ nhiên liệu hóa thạch, chăn nuôi và các bãi chôn lấp rác thải. Hai phân tử này có mối liên hệ mật thiết: Methane tạo ra hydro khi bị phân hủy trong khí quyển.
Mặc dù bản thân hydro không phải là chất gây ô nhiễm, nhưng nó gián tiếp góp phần làm Trái Đất ấm lên bằng cách hấp thụ các "chất tẩy rửa tự nhiên” có vai trò phá hủy methane, khí nhà kính có vòng đời ngắn hơn so với carbon dioxide.
Tác giả chính của nghiên cứu, ông Zutao Ouyang, Phó Giáo sư Mô hình hóa hệ sinh thái, ĐH Auburn (bang Alabama, Mỹ), cho biết: “Lượng hydro càng nhiều thì các chất tẩy rửa tự nhiên trong khí quyển càng ít, khiến methane tồn tại lâu hơn và do đó kéo dài tác động làm ấm khí hậu” .
Các tương tác của hydro với các chất tẩy rửa tự nhiên này cũng ảnh hưởng đến quá trình hình thành mây và dẫn đến sự hình thành các khí nhà kính khác như ozone và hơi nước trong tầng bình lưu. Ngoài ra, các nguồn hydro khác trong khí quyển kể từ năm 1990 còn bao gồm các vụ rò rỉ từ hoạt động sản xuất hydro công nghiệp. Hydro có thể được sản xuất bằng cách cho dòng điện chạy qua nước để tách nước thành hydro và oxy, một quá trình được gọi là điện phân.
Tuy nhiên, hiện nay phần lớn hydro vẫn được sản xuất từ khí tự nhiên hoặc than đá thông qua các quy trình tiêu tốn nhiều năng lượng và thải ra lượng lớn carbon dioxide. Mục tiêu lâu dài là sản xuất hydro “xanh” trên quy mô lớn bằng năng lượng tái tạo, song quá trình này vẫn có chi phí cao và lĩnh vực này đang đối mặt với nhiều rào cản đáng kể.